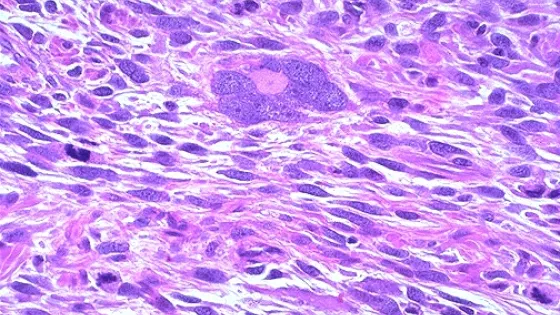
FEM034

- Российские ученые успешно разрушили злокачественную опухоль ультразвуком.
- Эксперимент проведен на лейомиосаркоме человека без нагрева и разрезов.
- Новый метод может стать альтернативой хирургическому и медикаментозному лечению сарком.
- Гистологический анализ подтвердил полное разрушение опухолевых клеток.
- Лейомиосаркома - агрессивная злокачественная опухоль мягких тканей.
- Метод основан на фокусировке высокоамплитудных ультразвуковых импульсов на патологической области.
- Опухоль разрушается механически, а не за счет ультразвукового нагрева.
«Идея нашего метода заключается в фокусировке периодической последовательности высокоамплитудных ультразвуковых импульсов миллисекундной длительности от излучателя, расположенного вне тела пациента, через кожу и здоровые ткани на патологическую область. Опухоль разрушается не за счет ультразвукового нагрева, а механически, при воздействии на опухоль нелинейных акустических волн с резкими перепадами давления», - пояснила руководитель проекта.